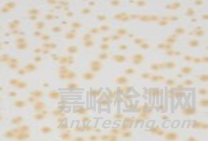

您當前的位置:檢測資訊 > 法規(guī)標準
嘉峪檢測網 2021-04-05 22:55
水性工業(yè)涂料本質特性
|
水的基本特性 不燃,無毒,無污染 經濟性,資源可持續(xù) 0℃結冰、100℃沸騰 極性強,溶解和分散離子物質 溶解少量氧氣和其他氣體 中性、酸性或堿性環(huán)境多功能性 高化學反應性,水解和腐蝕
生物必需性 |

|
水的本質 兩種元素,三個原子; 四個雜化軌道來自于氧2s,2px, 2py和2pz原子軌道,從氧核向外指向四面體的角; 不對稱的電荷分布,成為極性分子(α=114°29′,β= 104° 27′); 分子間氫鍵,氫核與鄰近水分子的孤對負電荷相互作用,產生一個能量約為分子O- H鍵十分之一的氫鍵。 |

|
水溶液結構
液態(tài)水是一種高度組織化的物質。 液態(tài)水中分子的詳細排列是不確定的?;诹切蔚谋Y構,每個水分子都與四個相鄰的水分子相連接。 由冰的結構衍生而來,一些額外的分子占據(jù)間隙空間與氫鍵網絡中的分子交換,水分子的相鄰分子平均數(shù)量從冰的4個增加到液體冰點的4.4個。水密度比冰大。 水具有已知最高的介電常數(shù)之一,在25°C時為78。介質介電常數(shù)越高,分離相反電荷所需的能量越低,使水成為離子物質的有效溶劑的因素之一。 |

|
有機樹脂水性化原理
水性化技術原理:聚合物分子被親水性物質包覆/化學接枝親水性基團,(或中和后)可用水稀釋。
外乳化:在水相加入乳化劑(離子型or非離子型)形成膠束,通過乳液聚合而成乳膠;或加入親水性物質,通過相反轉乳化而得。通常稱為乳液。
自乳化:在聚合物分子上接枝親水性基團(-COOH,-CH2-CH2-O-,-NH2等),(或中和后)可用水稀釋。通常稱為分散體。 |

|
水性樹脂宏觀形態(tài)
宏觀形態(tài)(乳狀液、微透明分散液、透明溶液) 大多數(shù)水溶性樹脂,不是真正溶于水(除聚乙烯醇、纖維素、聚丙烯酸),而是在有機溶劑的胺鹽溶液經水稀釋后,形成相對穩(wěn)定的聚合物膠體分散溶液。
|

|
水性樹脂微觀形態(tài)
非均相體系:乳膠粒子、聚合物聚集體微粒 游離親水性物質、中和劑、助溶劑等
|

|
水性樹脂稀釋粘度變化—水性分散體、水性樹脂
水性樹脂稀釋過程存在粘度峰
水性分散體不存在粘度峰,相比于樹脂溶液,粘度變化大
|

|
水性樹脂稀釋粘度變化—水性樹脂
水性樹脂粘度還與分子量、助溶劑極性和量有關。
|

|
水性樹脂中溶劑的分布
溶劑不均勻分布于水相和聚合物相;影響體系粘度、微粒聚集成膜、水分揮發(fā)和穩(wěn)定 |

|
水性工業(yè)涂料干燥過程
水與有機溶劑揮發(fā) 強的相互作用偏離拉烏爾定律 相對濕度影響水分揮發(fā),對溶劑影響小 會有共沸效應 水的熱容和汽化熱異常大 (沸點,醋酸丁酯(126℃)揮發(fā)比正丁醇(118℃)快) 濕階段 混合溶劑揮發(fā)速度受控于蒸氣壓、表面溫度、相對濕度、空氣速度、和表面積與體積比等因素影響。與漆膜厚度是一次方關系。 干階段 混合溶劑揮發(fā)速度決定于溶劑分子擴散速度。與漆膜厚度是二次方關系。 |

|
水性涂料涂膜致密性 成膜過程涉及微粒間和分子間擴散
非均相膜(相對于溶劑型涂料)
![]() |
|
水性涂料涂膜結構及組成
非均相致密涂膜;存在不同物質的富集區(qū);親水性物質/基團仍部分殘留在涂膜中。 |

|
水性工業(yè)涂料的腐蝕 ![]() |

|
閃銹概念和評價
ISO12944-4 defines flash rusting as ‘slight rust formation on a preparedsteel surface soon afterpreparation’ 譯:在處理好的鋼表面快速形成的輕微銹蝕
ASTMD 610-85 (1989)評定涂漆鋼表面生銹程度的標準試驗方法
涂料“閃銹”影響因素 水性聚合物類型(重要因素) 成膜過程中的相對濕度(非常重要的因素) 體系pH值(低重要性的因素) 金屬類型(重要因素)金屬焊縫處(埋弧焊)>鑄鐵>碳鋼 |

|
水性工業(yè)涂料應用經典范例—電泳涂裝
適應復雜形狀件全面涂裝、成膜均勻、膜薄高性能、自動化。 |


非均相膜(相對于溶劑型涂料)
來源:Internet